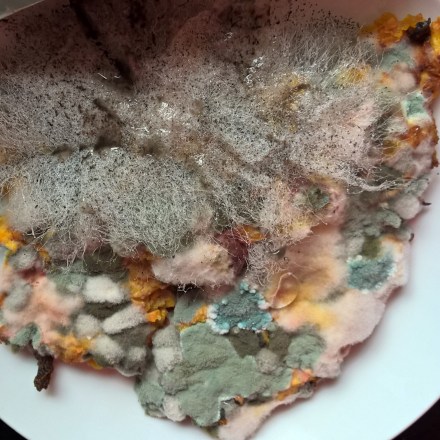
Copyright by "Sofies viele Welten"

Ich spüre einen tiefen Sog, der mich nach unten zieht. Wie in einem Strudel beginne ich mich um die eigene Achse zu drehen und zu versinken. Gerade noch hat das Kaminfeuer warm geflackert. Mein Blick folgte den Flammen. Dann begann die Verwandlung. Nur einen Hand vom Fliegenpilzpulver in die Glut hat mich fertig für den Aufbruch gemacht. Pilze sind zum Reisen wesentlich komfortabler als Besen. Es ist traurig, wie viele Hexen unter flugbedingten Verschleißerscheinungen leiden. In meiner Zunft ist das wohl die häufigste Ursache für Arbeitsausfälle. Dieses Risiko! Nein, da gönne ich mir lieber hin und wieder einen kleinen Pilzzauber, um lautlos und unsichtbar in die andere Welt zu wandern. Durch den Kamin steige ich mit dem Rauch nach oben oder suche mir vorab eine Baumpforte und bitte um Einlass ins Erdreich. In der Hölle treffe ich bei Zeiten den Papst. Auch er holt seine Kräutlein für den Klosterlikör bei Frau Holle. Aber: „Psssssst! Lasst die Gläubigen schlafen!“
Mehr Infos zu den ABC-Etüden findest du auf dem Blog von Christiane „Irgendwas ist immer“.